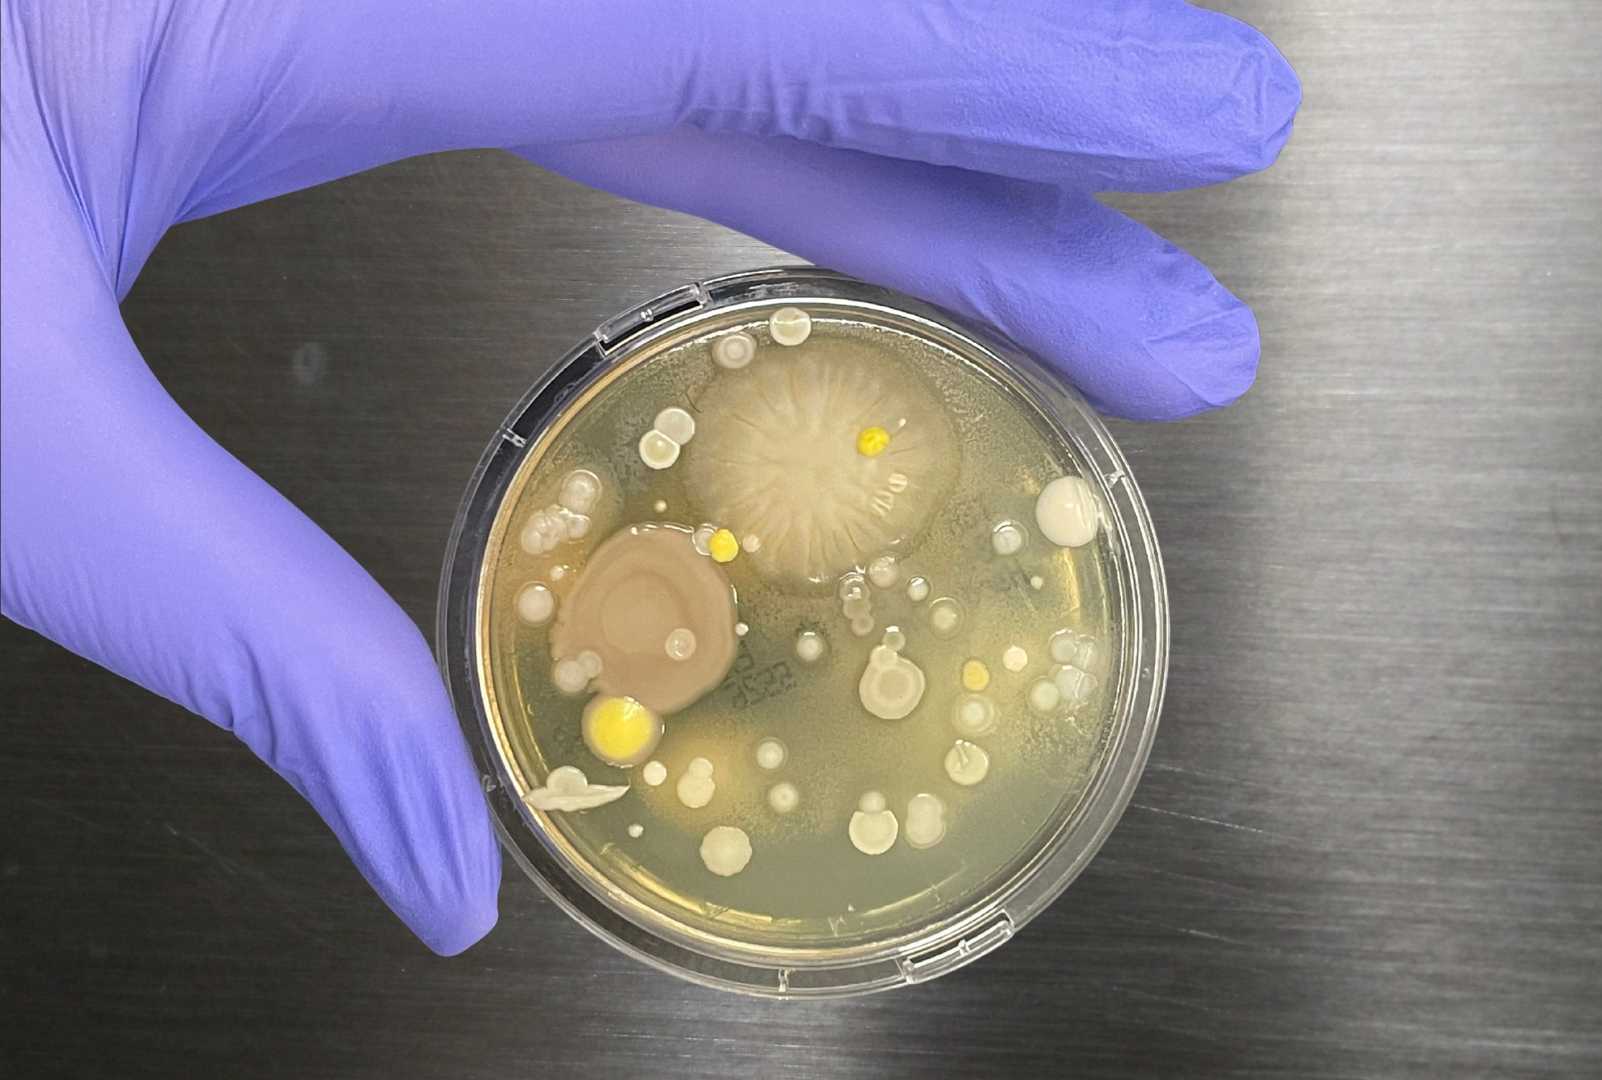
Bioburden depicted in petri dish

Demonstrating Correlation of Alternative Microbiological Method to Traditional Plate Count Method
The pharmaceutical industry is increasingly seeking modern microbial methods (alternative microbiological methods) to comply with evolving regulatory standards like Annex 1 for contamination control and to improve efficiency. A critical aspect of adopting alternative methods is demonstrating their correlation to traditional plate counts, often involving a variety of microorganisms, such as those outlined in USP <61>, USP <62>, E.P. 2.6.12, EP 2.6.13 and JP 4.05.
This research presents a comprehensive comparison study to evaluate the performance of the Sievers Soleil Rapid Bioburden Analyzer against the compendial method involving 11 microorganisms and a combination of common water isolates, which are tested across multiple laboratory sites, analysts, and instruments. This research was originally presented as a poster at the PDA Pharmaceutical Microbiology Conference.
The Sievers Soleil microorganism verification study aligns with parameters mentioned in USP <1223> “VALIDATION OF ALTERNATIVE MICROBIOLOGICAL METHODS”. The results demonstrate:
- The Sievers Soleil Rapid Bioburden Analyzer successfully detects and quantifies Gram-positive, Gram-negative bacteria, yeasts, and molds, showing strong correlation with traditional plate counts in ultrapure water (UPW)
- Performance across key metrics including accuracy, linearity, precision, range, robustness, and ruggedness, with a Limit of Detection (LOD) of 5 CFU/100 mL
- The Sievers Soleil is a reliable, rapid, and sensitive microbial enumeration method for pharmaceutical water testing
Background: Implementing Modern Microbial Methods (MMMs) for Annex 1 Compliance
The publication of Annex 1 sparked increased interest among pharmaceutical companies in implementing Modern Microbial Methods (MMMs). MMMs represent a significant advancement toward obtaining bioburden results to enable proactive decision-making, instead of reactive.
Alternative rapid micro methods offer a promising alternative to traditional plating methods by enhancing efficiency and reliability in microbial testing. However, comprehensive correlation studies and adherence to pharmacopoeial guidelines, such as USP <1223> criteria, remain essential to ensure their efficacy and reliability for widespread adoption.
When selecting an MMM as a process analytical technology (PAT), it is crucial to ensure correlation with traditional methods.
Global pharmacopoeias recommend comparing results from alternative methods to compendial methods, typically using common microorganisms. The Japanese Pharmacopoeia specifically suggests using microorganisms in a starved state to simulate real-world contamination events.
In response to these guidelines and industry needs, a comprehensive comparison study was conducted between the Sievers Soleil Rapid Bioburden Analyzer and traditional bioburden test plating methods. This extensive study involved:
- 11 individual microorganisms and a mixed culture
- Two laboratory sites
- Six analysts
- Six instruments
The evaluation followed USP <1223> (Validation of Alternative Microbiological Methods) guidelines, assessing:
- Range
- Linearity
- Robustness
- Precision
- Reproducibility
- Ruggedness
This research presents the methodology, results, and conclusions of the correlation study, demonstrating the efficacy and reliability of the Sievers Soleil Rapid Bioburden Analyzer as an alternative to traditional plating methods in pharmaceutical microbial testing.
Study Design: Comparison of Traditional Plating Methods to Rapid Bioburden Analysis for Bioburden Detection
As part of the daily start up, Negative Controls and System Suitability Standards were run and had to pass the acceptance criteria before testing could begin.
Working stock solutions were created for the following organisms:
- A. brasiliensis
- B. cepacia
- B. diminuta
- B. subtilis
- C. albicans
- E. coli
- P. aeruginosa
- R. pickettii
- S. aureus
- S. enterica
- S. maltophilia
- Mixture of B. diminuta, R. pickettii, S. maltophilia, & B. cepacia
Sample Preparation:
- Concentrations targeted at 0.05, 0.1, 1, 10, and 100 CFU/mL
- Sample volumes were made in 250mL bottles then aliquoted into 100mL samples—one run on Soleil, one for plating
- Serial dilutions were performed to achieve desired concentrations, and solutions were added to buffered Water For Cell Culture (WFCC) to maintain cell integrity.
Traditional Plating Method:
- Agar plates were prepared using:
- Tryptic Soy Agar (TSA) for bacteria
- Sabouraud Dextrose Agar (SDA) for fungi (as directed per USP <61> and USP <62>)
- Sample filtration
- Each solution filtered through a manifold onto a sterile filter
- Filter aseptically transferred to the appropriate agar plate Incubation
- Plates incubated in a cell incubator Minimum incubation period: 3 days
Note: For the 100 CFU/mL samples, flood plates were used.
Results and Conclusions: Demonstration of Detection and Quantification Per Criteria Outlined in USP <1223>
The average % recovery is detailed in the chart below. Average linearity of all organisms was 0.983 and average coefficient of variation (CV%) was 28% for Soleil and compendial plates.

The comprehensive correlation study between the Sievers Soleil Rapid Bioburden Analyzer and traditional plating methods met the criteria outlined in USP <1223>.
- Detection and Quantitation: Successfully detected and quantified Gram-positive bacteria, Gram-negative bacteria, Yeasts, and Mold
- Performance Metrics: Demonstrated acceptable Accuracy, Linearity, Precision, Range, Robustness, and Ruggedness
- Sensitivity: Limit of Detection (LoD): 0.05 CFU/mL; Limit of Quantitation (LoQ): ≤1.0 CFU/mL
In conclusion, the Sievers Soleil demonstrated correlation to traditional plate counts in CFU/mL. The above criteria demonstrates that the Soleil is a reliable, efficient, sensitive alternative to compendial plating methods.
Modern Microbial Methods with Sievers Soleil
The Sievers Soleil Rapid Bioburden Analyzer serves as a promising complementary tool to compendial testing, delivering near real-time, actionable data with demonstrated correlation to traditional plate counts in accordance with USP <1223> guidelines. As a Process Analytical Technology (PAT) solution that empowers manufacturers to implement more robust, risk-based contamination control strategies, Soleil can enhance overall process control by enabling rapid detection of microbial excursions and triggering same-day corrective actions.
Download Now: Sievers Soleil Rapid Microbial Method Verification Testing for USP <1223>
Learn more about the Sievers Soleil Rapid Bioburden Analyzer or our entire portfolio of microbial detection solutions.

Authors:
- Meg Provenzano
-
Meg Provenzano is the Global Product Manager for Sievers endotoxin instruments at Veolia. She has over 10 years of experience in the bacterial endotoxin testing industry and has held several positions in Quality Control, Technical Support, and Product Management. Prior to joining Veolia, Meg was a Product Manager with Charles River Laboratories. She is customer-centric and enjoys hands-on problem solving, whether for technical issues, assay assistance, or software. Meg holds a B.S. in Marine Science and Biology from Coastal Carolina University where she focused on Bottlenose Dolphin population research.
- Irma Perez
-
Irma Perez is a Product Applications Manager at Veolia, specializing in microbiology applications for Sievers Instruments. She has over 10 years of microbiology expertise spanning life sciences, environmental sciences, water treatment facilities, and analytical instrumentation. In her current role, she develops and implements analytical methods for endotoxin and bioburden testing platforms. Previously, Irma directed experiments for rapid diagnostic microbiology assay development, including antibiotic susceptibility testing and identification. She is driven by a philosophy rooted in environmental stewardship and responsibility for public health. Irma holds a B.S. in Environmental Science from the University of Arizona.
- Cort Lawrence
-
Cort Lawrence is a Lead Researcher serving as the Application Support Specialist for the Sievers Soleil instrument product line at Veolia. Since earning his Bachelor of Science in Microbiology from the University of Arizona in 2016, Cort has worked in varying capacities as a microbiology subject matter expert, with a particular focus on flow cytometry. Known for his hands-on problem-solving approach, Cort is dedicated to advancing biodetection technology and delivering innovative solutions to the biotechnology industry. When not in the lab, he enjoys reading, swimming, and exploring the outdoors.
- Matt Shallenberger
-
Matt Shallenberger is a Product Application Specialist at Veolia specializing in endotoxin testing and was involved in the research and development of the Soleil rapid bioburden monitoring platform. Prior to his roles in the instrumentation industry, Matt was a teacher of laboratory courses in microbiology at the University of Arizona. He holds a B.S in Biochemistry from the University of Arizona, with a focus on fungal genetics and industrial microbial biotechnology.
- Jake Vincent
-
Jake Vincent is the Biodetection Specialist and Advanced Lead Researcher for the Sievers R&D group at Veolia, specializing in the development of biodetection analytical instrumentation. A key contributor to the Sievers Eclipse Endotoxin Analyzer, Vincent was responsible for designing the predeposited standards featured in the consumable device. His expertise is reflected in the co-authored publication, "Miniaturization, Parallelization, and Automation of Endotoxin Detection by Centrifugal Microfluidics," which appeared in Analytical Chemistry. Prior to his current role, Vincent contributed to the analytical methods for flavivirus vaccine testing at Inviragen and Takeda Vaccines, including performing clinical trial testing for the dengue vaccine Qdenga. He holds a B.S. from Colorado State University.
- Gary Silver
-
Gary Silver is an Advanced Lead Researcher in the R&D group at Veolia, specializing in the development of biodetection analytical instrumentation. As a key contributor to the Sievers Eclipse Endotoxin Analyzer, Gary was responsible for the development and validation of manufacturing processes, analytical methodology, and product stability. Prior to joining Veolia, Gary spent 20 years in the biopharmaceutical industry with various roles in R&D, Quality Control, and Quality Assurance. He holds a PhD in Chemistry from the University of Colorado, where his research focused on biochemical pathways and mechanisms of hydrocarbon emissions from aspen trees.
- Anne Little
-
Anne Little is a Project Engineer supporting the Sievers Instrument product line at Veolia. She holds a degree in Biology and Chemistry from Colorado State University-Pueblo. Anne's career has taken her through multiple sectors, beginning in water treatment before transitioning to the pharmaceutical industry.